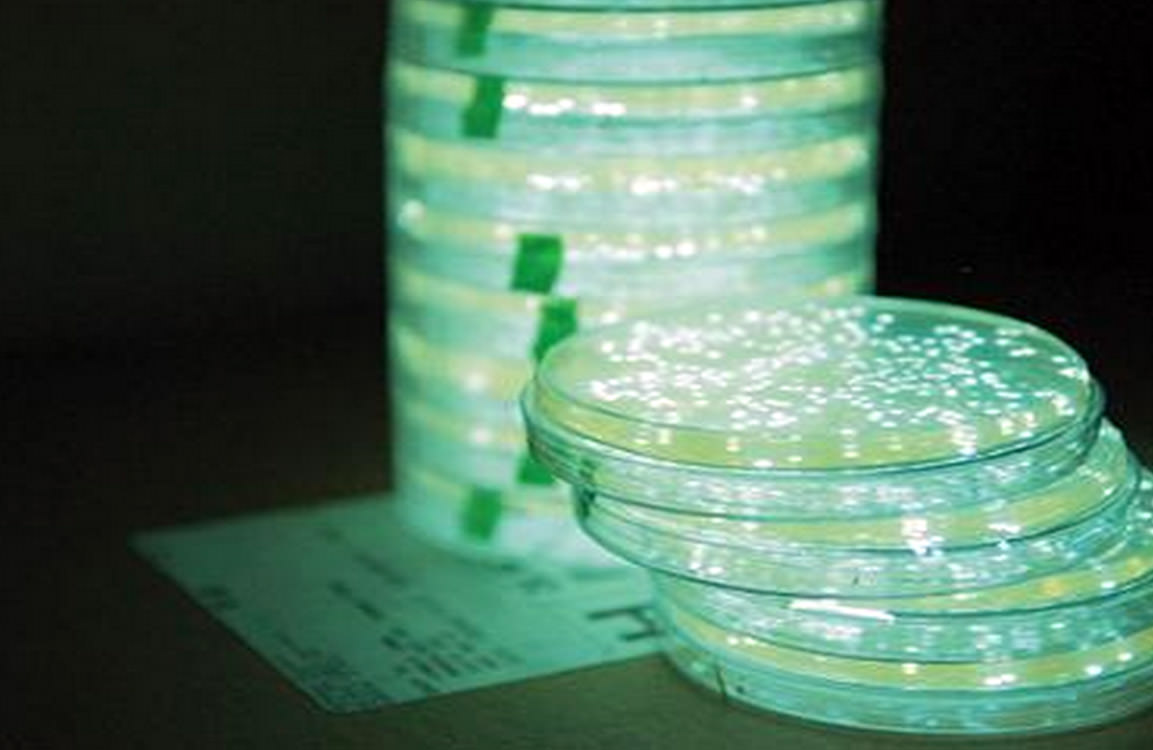
Nanopartikülleri Kullanarak Parlayan Bitkiler Geliştirildi

Parlayan Bitkiler: Nanopartiküller, bitkilere eşsiz ve doğal olarak bitki benzeri olmayan özellikleri ve yetenekleri vermeye çalışan bitki nanobiyonikleridir.
Strano’nun laboratuvarı tarafından öncülük edilen yeni bir araştırma alanı olan bitki nanabiyonikleri, bitkilere farklı nanopartikül türleri yerleştirerek yeni özellikler kazandırmayı amaçlıyor. Grubun amacı, elektrikli cihazlar tarafından gerçekleştirilen işlevlerin birçoğunu devralacak mühendislik yapmaktır. Araştırmacılar daha önce patlayıcı madde tespit edebilen ve bu bilgileri bir akıllı telefona iletebilen bitkilerin yanı sıra kuraklık koşullarını izleyebilen bitkiler tasarladılar.
Dünya çapındaki enerji tüketiminin yaklaşık yüzde 20’sini oluşturan aydınlatma, mantıklı olan bir sonraki hedef gibi gözüküyordu.
Parlayan bitkiler geliştirmek için MIT (Massachusetts Institute of Technology) ekibi lümenleştiriciden ilham aldı, bu ateşböceklerine parlaklık veren enzimdir. Lusiferaz, lusiferin adı verilen ve ışığın yayılmasına neden olan bir molekül üzerinde görev yapar. A yardımcı enzimi adı verilen bir başka molekül, lusiferaz aktivitesini engelleyebilen bir reaksiyon yan ürününün çıkarılmasıyla sürecin ilerlemesine yardımcı olur.
PARILTILI BİTKİLER
Düşünsenize salonunuzdaki mütevazi bitkiler parlayıp etraflarındaki alanı küçük botanik lambalar gibi aydınlatsa nasıl olurdu? MIT (Massachusetts Institute of Technology) mühendislerinin son zamanlardaki yaptıkları çalışma sayesinde, bu hayaller yakında gerçekleşebilir.
Nanopartiküller bitkiye girdikten sonra bitkilerin neredeyse dört saat boyunca parlayan loş bir ışık vermesine neden oluyor.
Araştırma ekibi, nispeten küçük bir başarı (hemen ticarete dönüştürülmesi mümkün olmasa da) gibi görünse de, tekniğin daha ileri bir aşamaya taşınmasıyla parlayan bitkilerin parlaklığını ve zamanın uzunluğunu artırabileceğine inanıyorlar.
Araştırma ekibinden Strano’ya göre, “Vizyon, bir masa lambası görevi görecek bir bitki yapmaktır – prize takmanızı gerektirmeyen bir lamba. Işık, eninde sonunda, bitkinin kendisinin enerji metabolizması tarafından sağlanır.”
BİTKİ NANOBİYONİKLERİ
Araştırmacılar, bu teknolojinin basit bitki bazlı masa lambalarının ötesine geçebileceğini öngörüyorlar. Teknolojiyi ölçeklendirebildikleri ve geliştirebildikleri takdirde, caddelerdeki ağaçları kendi kendine çalışan sokak lambalarına dönüştürmenin gelecekte mümkün olabileceğini söylüyorlar. İndi əyləncə və real hissləri evdən çıxmadan yaşamaq daha asandır. Sadəcə bir neçə kliklə onlayn kazino dünyasına daxil ola bilərsən və burada müxtəlif oyunlar, bonuslar və qazanmaq fürsətləri səni gözləyir. Əgər daha canlı və interaktiv təcrübə arayırsansa, canlı kazino seçimi ilə real krupiyerlərlə masalara qoşula bilərsən. Həm əylənmək, həm də qazanmaq istəyənlər üçün bu platformalar idealdır. Pinco brendi bu sahədə öz fərqini göstərərək oyunçulara güvənli və keyfiyyətli oyun imkanı təqdim edir.
Proje, Strano’nun laboratuvarının öncülüğünde yeni bir araştırma sektörünün parçasıdır: nanopartiküller, bitkilere eşsiz ve doğal olarak bitki benzeri olmayan özelliklerini ve yeteneklerini vermeye çalışan bitki nanobiyonikleridir.
Strano, “Bitkiler kendi kendine onarabilir, onlar kendi enerjilerine sahiptir ve zaten dış çevreye uyarlanmıştır. Bunun zamanı gelen bir fikir olduğunu düşünüyoruz. Bitki nanobiyolojisi için mükemmel bir problem” dedi.
Kaynak: Popüler Tarım
Çok iyi bir çalışma olmuş.
Çok güzel bir çalışma enerji tasarrufu olacak bizler için